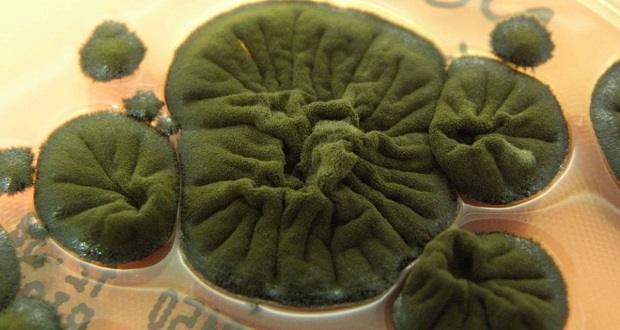
راز عجیب قارچ چرنوبیل

پس از چهار دهه، دانشمندان به راز عجیب قارچ چرنوبیل پی بردند و متوجه چگونگی انطباق آن با محیط شدند. ادامه مطلب را از دست ندهید.
منطقه ممنوعه چرنوبیل شاید برای انسانها کاملا خطرناک و غیرقابل سکونت باشد، اما برای تمام موجودات زنده این طور نیست. پس از انفجار راکتور شماره چهار نیروگاه هستهای چرنوبیل در حدود 40 سال پیش، طبیعت به تدریج به این منطقه بازگشته است. گونههای مختلف جانوری و گیاهی نه تنها در آنجا زنده مانده، بلکه با شرایط جدید سازگار شده و حتی در برخی موارد رشد کردهاند.
یکی از دلایل این موضوع میتواند نبود حضور انسان باشد، اما نکته جالبتر این است که برای برخی موجودات، خودِ محیط رادیواکتیو ممکن است حتی مزیت ایجاد کرده باشد. در یکی از آلودهترین ساختمانهای جهان، دانشمندان نوعی قارچ سیاه رنگ را کشف کردهاند که روی دیوارههای داخلی راکتور رشد میکند و به خوبی در این شرایط سخت دوام آورده است.
راز عجیب قارچ چرنوبیل
این قارچ با نام Cladosporium sphaerospermum شناخته میشود. پژوهشگران حدس میزنند که رنگدانه تیره آن، یعنی ملانین، ممکن است به آن کمک کند تا از تابش یونیزه کننده انرژی بگیرد و این فرایند از نظر مفهومی شبیه فتوسنتز در گیاهان است. این ایده هنوز در حال بررسی است و حتی نامی مشابه هم برای آن پیشنهاد شده و محققان به آن رادیوسنتز میگویند.
اما نکته واقعا عجیب درباره قارچ C. sphaerospermum این است که با وجود اینکه شواهد نشان میدهد در محیطهای دارای تابش یونیزه کننده به خوبی رشد میکند، هنوز هیچ توضیح قطعی برای نحوه یا دلیل این توانایی وجود ندارد. ایده رادیوسنتز مطرح شده، اما در حد یک فرضیه باقی مانده و اثبات آن بسیار دشوار است. این ماجرا به اواخر دهه 1990 برمیگردد، زمانی که نلی ژدانوا و تیمش از آکادمی ملی علوم اوکراین به منطقه ممنوعه چرنوبیل رفتند تا بررسی کنند آیا در اطراف راکتور ویران شده، هیچ شکلی از حیات وجود دارد یا نه.
نتایج این بررسی شگفتانگیز بود: آنها یک اجتماع کامل از قارچها را پیدا و در مجموع 37 گونه مختلف را شناسایی کردند. بیشتر این قارچها رنگهای تیره تا کاملا سیاه داشتند و مقدار زیادی ملانین در ساختارشان وجود داشت. در این میان، C. sphaerospermum از همه غالبتر بود و نکته جالبتر اینکه در نمونههایی که بیشترین میزان آلودگی رادیواکتیو را داشتند نیز حضور پررنگی داشت.
- این قارچ جادویی آب را تبدیل به یخ میکند
- دانشمندان هشدار دادند: یک قارچ کشنده و مقاوم در برابر دارو، مردم سراسر جهان را تهدید میکند
قارچ چرنوبیل در برابر تابش یونیزه کننده مقاوم است
گرچه کشف اولیه این قارچ در چرنوبیل بسیار غیرمنتظره بود، اما تحقیقات بعدی این موضوع را حتی عجیبتر کرد. اکاترینا داداچووا، متخصص رادیوفارماکولوژی، و آرتورو کاسادوال، ایمونولوژیست، به همراه تیمی از پژوهشگران در کالج پزشکی آلبرت اینشتین آمریکا نشان دادند که این قارچ برخلاف بیشتر موجودات زنده، در برابر تابش یونیزه کننده آسیب جدی نمیبیند. به بیان ساده، چیزی که برای اکثر جانداران مرگبار است، برای این قارچ به نظر نمیرسد همان اثر مخرب را داشته باشد.
تابش یونیزه کننده نوعی انرژی بسیار پرقدرت است که میتواند الکترونها را از اتمها جدا و آنها را به حالت باردار (یونی) تبدیل کند. گرچه این فرآیند در نگاه اول ساده به نظر میرسد، اما در واقع میتواند اثرات مخربی داشته باشد، زیرا باعث شکسته شدن مولکولها، اختلال در واکنشهای حیاتی سلولی و حتی آسیب جدی به DNA میشود. برای انسانها این نوع تابش بسیار خطرناک است، هرچند همین ویژگی در پزشکی برای نابودی سلولهای سرطانی مورد استفاده قرار میگیرد، چون این سلولها نسبت به آن حساستر هستند.
اما نکته شگفت انگیز این است که قارچ C. sphaerospermum نه تنها در برابر این تابش مقاوم است، بلکه در برخی شرایط حتی رشد بهتری هم نشان میدهد. علاوه بر این، آزمایشها نشان دادهاند که تابش یونیزه کننده میتواند رفتار رنگدانه ملانین در این قارچ را تغییر دهد، یافتهای غیرمنتظره که هنوز به طور کامل درک نشده و نیازمند پژوهشهای بیشتری است.
- قارچها جای سیلیکون را در ساخت حافظههای کامپیوتری میگیرند!
- نه شپش، نه قارچ زامبی، بزرگترین انگل قرن 21، همین گوشی هوشمند شماست
در مقالهای که در سال 2008 توسط داداچووا و کاسادوال منتشر شد، برای اولین بار این ایده مطرح شد که ممکن است یک مسیر زیستی شبیه به فتوسنتز در این قارچ وجود داشته باشد. بر اساس این فرضیه، قارچ C. sphaerospermum و برخی گونههای مشابه میتوانند انرژی حاصل از تابش یونیزه کننده را جذب و آن را به نوعی انرژی قابل استفاده برای رشد تبدیل کنند و این درست همان طور است که گیاهان نور خورشید را با استفاده از کلروفیل به انرژی شیمیایی تبدیل میکنند.
اما نکته مهمتر این است که ملانین فقط نقش جذب کننده انرژی را ندارد، بلکه همزمان مثل یک سپر محافظ عمل میکند و از سلولهای قارچ در برابر آسیبهای شدیدتر این تابشها محافظت میکند. این ایده با نتایج یک پژوهش در سال 2022 نیز همخوانی دارد؛ مطالعهای که در آن قارچ C. sphaerospermum به فضا برده شد و در بیرون از ایستگاه فضایی بین المللی قرار گرفت تا در معرض مستقیم تابش کیهانی قرار بگیرد.
در این آزمایش، سنسورهایی در زیر ظرف کشت قرار داده شده بودند. دادهها نشان دادند که وقتی قارچ روی سطح قرار داشت، میزان تابشی که از آن عبور میکرد کمتر از زمانی بود که فقط محیط کشت ساده (آگار) وجود داشت. به عبارت دیگر، این قارچ تا حدی توانست مانند یک لایه محافظ عمل کند و بخشی از تابش کیهانی را کاهش دهد.
هدف این پژوهش اصلا اثبات وجود رادیوسنتز نبود، بلکه بیشتر بررسی این موضوع بود که آیا میتوان از این قارچ به عنوان یک لایه محافظ در برابر تابش در مأموریتهای فضایی استفاده کرد یا نه و این ایده از نظر کاربردی بسیار جذاب است. اما با وجود این آزمایشها، هنوز یک سؤال اساسی بی پاسخ مانده است: این قارچ دقیقا چه میکند؟
- کشف عنکبوت زامبی، توجه دانشمندان را به قارچ زامبی کننده جلب کرد
- باز هم چین، باز هم فاجعه؛ مشاهده یک بیماری قارچی ترسناک
قارچ چرنوبیل چه کاری انجام میدهد؟
تا امروز، دانشمندان نتوانستهاند نشان دهند که این قارچ واقعا از تابش یونیزه کننده برای تثبیت کربن استفاده میکند یا اینکه این تابش مستقیما باعث تولید انرژی متابولیکی برای آن میشود. همچنین هیچ مسیر زیستی مشخصی برای برداشت انرژی از این نوع تابش تأیید نشده است.
همانطور که تیمی از جمله نیلز اوروش از دانشگاه استنفورد اشاره کردهاند، رادیوسنتز واقعی هنوز اثبات نشده، چه برسد به اینکه نشان داده شود این تابش میتواند کربن غیرآلی را به ترکیبات پرانرژی تبدیل کند. با این حال، ایده رادیوسنتز همچنان جذاب است. اما شاید حتی جالبتر این باشد که با وجود ندانستن سازوکار دقیق، این قارچ به شکلی ناشناخته میتواند اثرات یکی از خطرناکترین انواع انرژی برای انسان را کاهش دهد.
این پدیده فقط محدود به یک گونه قارچ نیست. برای مثال، یک مخمر سیاه به نام Wangiella dermatitidis وقتی در معرض تابش یونیزه کننده قرار میگیرد، حتی بهتر رشد میکند. در مقابل، گونه دیگری از قارچها با نام Cladosporium cladosporioides واکنش متفاوتی نشان میدهند و در برابر تابش گاما یا فرابنفش، رشدش افزایش پیدا نمیکند، اما میزان تولید ملانین در آن بالا میرود. به بیان ساده، قارچهای مختلف واکنشهای متفاوتی به تابشهای پرانرژی دارند و برخی سریعتر رشد میکنند، برخی فقط رنگدانه محافظ بیشتری تولید میکنند و برخی هم هر دو یا هیچکدام را نشان نمیدهند.
با این اوصاف، رفتاری که در C. sphaerospermum دیده میشود، یک ویژگی عمومی در همه قارچهای دارای ملانین نیست. این سؤال مطرح میشود که آیا این واکنش یک نوع سازگاری تکاملی است که به قارچ اجازه میدهد از تابشهای بسیار پرانرژی که برای بیشتر موجودات کشنده هستند نوعی مزیت یا منبع انرژی بسازد؟ یا اینکه صرفا یک واکنش دفاعی در برابر شرایط استرسزا است که به آن کمک میکند در محیطهای سخت دوام بیاورد، بدون اینکه واقعا از آن تابش تغذیه کند؟
در حال حاضر، پاسخ قطعی برای این پرسش وجود ندارد. اما آنچه روشن است این است که این قارچ ساده و تیره رنگ به طریقی ناشناخته با تابش یونیزه کننده تعامل دارد؛ به شکلی که هم در محیطهای بسیار خطرناک زنده میماند و هم شاید حتی بتواند در آنها رشد هم بکند و این یادآوری میکند که زندگی، در شرایط غیرممکن هم میتواند راهی برای ادامه پیدا کند.
گجت نیوز آخرین اخبار تکنولوژی، علم و خودرو

مطلب جالبی بود.